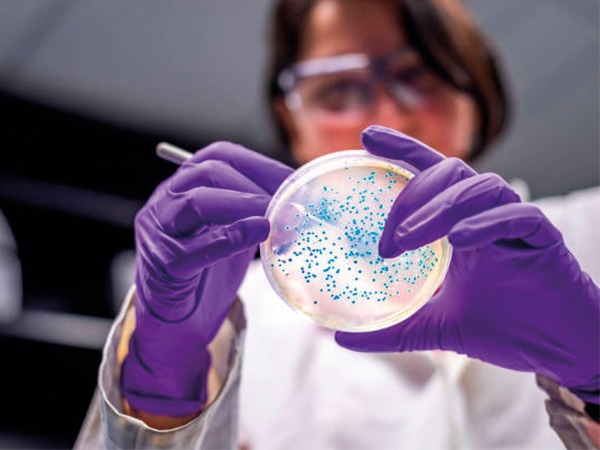

Causan superbacterias más de un millón de muertes al año: The Lancet
La Organización Mundial de la Salud (OMS) tiene varios años lanzando alertas mundiales sobre las superbacterias, un grupo de microbios catalogados como críticos por su resistencia a los antibióticos y por representar una gran amenaza en hospitales con pacientes graves que requieren respiradores y catéteres, como ha sucedido de manera frecuente durante la actual pandemia por COVID-19 en casi todo el planeta.
La lista, hasta ahora, la conforman seis microbios que reúnen dos condiciones que los hacen especialmente peligrosos: son altamente virulentos y resisten muy bien a los antibióticos. Se trata de, Enterococcus faecium, Staphylococcus aureus, Klebsiella pneumoniae, Acinetobacter baumannii, Pseudomonas aeruginosa y Enterobacter spp. Para una más rápida identificación, fueron agrupados bajo el acrónimo llamado ESKAPE.
La OMS afirmó en 2017 que estos microbios resistentes a los antibióticos se están multiplicando por todo el mundo por factores como el uso excesivo de antibióticos, tanto para tratar enfermedades humanas como animales en las granjas, y urgió a las y los científicos a desarrollar antibióticos capaces de doblegarlos.
Superbacterias, un problema global
De acuerdo con un artículo publicado el pasado 26 de enero en la National Geographic España, bajo la firma de David Miranda, un nuevo estudio publicado por la revista médica The Lancet estima que 1.27 millones de personas perdieron la vida en 2019 a causa de estas bacterias.
"La resistencia antimicrobiana supone una seria amenaza para la salud en todo el planeta", afirman los autores de esta investigación, la más completa del mundo hasta el momento realizada con datos de 471 millones de personas de 204 países distintos, en la que analizaron el impacto sobre la salud de 23 patógenos y de 88 combinaciones de patógenos y medicamentos.
En la investigación, destaca el periodista, no solo tuvieron en cuenta las defunciones causadas por estas bacterias, sino también los casos en los que se produjo un fallecimiento con este tipo de bacteria, aunque no fuera la causa principal de la muerte. Esto les ha permitido analizar de un modo mucho más detallado y transversal la incidencia de las superbacterias en las sociedades.
En 2016, el Review on Antimicrobial Resistance estimó que en 2050 la cifra de muertes anuales causadas por estos microbios se acercará a los 10 millones. Desde el inicio de la pandemia de COVID-19 se han producido 5.62 millones de defunciones en todo el mundo.
"Estos microbios resistentes a los antibióticos habrían sido la tercera causa de muertes a nivel mundial, solo por detrás de las cardiopatías isquémicas y los ataques al corazón", estiman los investigadores en el estudio. "En cualquier métrica", prosiguen, "las bacterias resistentes a los antibióticos son una de las principales amenazas a la salud pública global".
Si le interesa leer el artículo completo, puede ingresar a la siguiente liga:
https://www.nationalgeographic.com.es/ciencia/superbacterias-causan-mas-millon-muertes-ano_17804